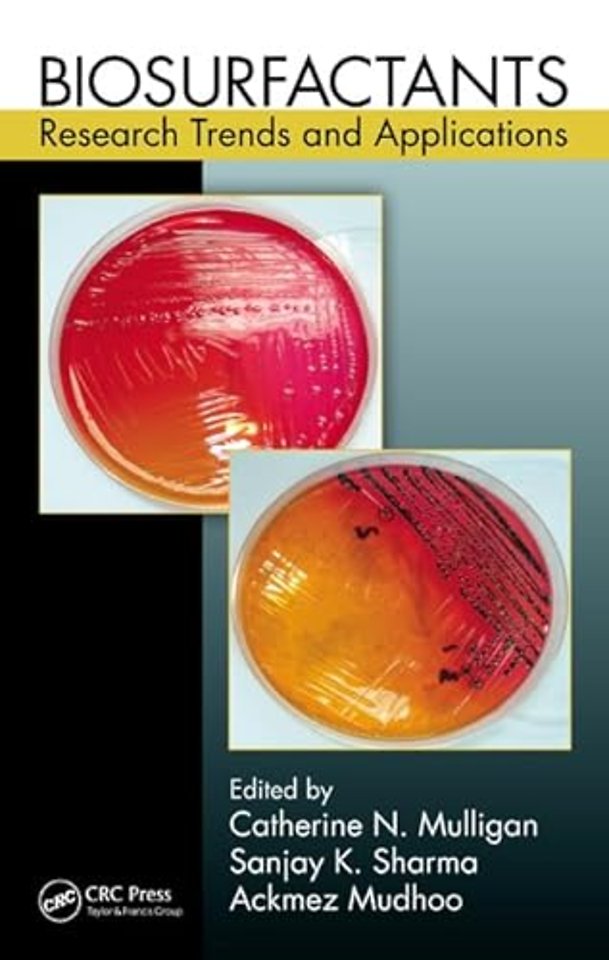

Biosurfactants
Research Trends and Applications
Gebonden Engels 2014 1e druk 9781466518230Samenvatting
Microbially derived surfactants, called biosurfactants, provide a promising alternative to synthetic surfactants, displaying better availability and being generally nontoxic and biodegradable. Biosurfactants also have the advantage of diverse chemical properties and the potential to be less expensive. They demonstrate properties such as reducing surface tension, stabilizing emulsions, and promoting foaming. With many promising research results, a consolidated resource of biosurfactant knowledge is needed to build a framework for further development of applications. Biosurfactants: Research Trends and Applications fills this need, covering the latest research and development on relevant aspects of biological, biochemical, and physical processes and applications of biosurfactants.
This book reviews current knowledge and the latest advances, strategies for improving production processes, and the status of biosynthetic and genetic regulation mechanisms for microbial surfactants. Chapters present research findings on specific biosurfactants, such as high surface activity rhamnolipids, yeast-derived sophorolipids, lipopeptides, and trehalose lipids that have potential for environmental, industrial, and medical uses. The book also describes sources and characteristics of marine microbial biosurfactants, biosurfactants made from food processing by-products and biosurfactants used in the food industry, and biosurfactants for green synthesis of nanoparticles.
The text presents applications of biosurfactants in environmental industries and examines interactions between metals and various classes of biosurfactants and related metal remediation technologies. The final chapter reviews the state of the art of biosurfactants and their applications, and proposes approaches to overcome any challenges.
Specificaties
Lezersrecensies
Rubrieken
- advisering
- algemeen management
- coaching en trainen
- communicatie en media
- economie
- financieel management
- inkoop en logistiek
- internet en social media
- it-management / ict
- juridisch
- leiderschap
- marketing
- mens en maatschappij
- non-profit
- ondernemen
- organisatiekunde
- personal finance
- personeelsmanagement
- persoonlijke effectiviteit
- projectmanagement
- psychologie
- reclame en verkoop
- strategisch management
- verandermanagement
- werk en loopbaan